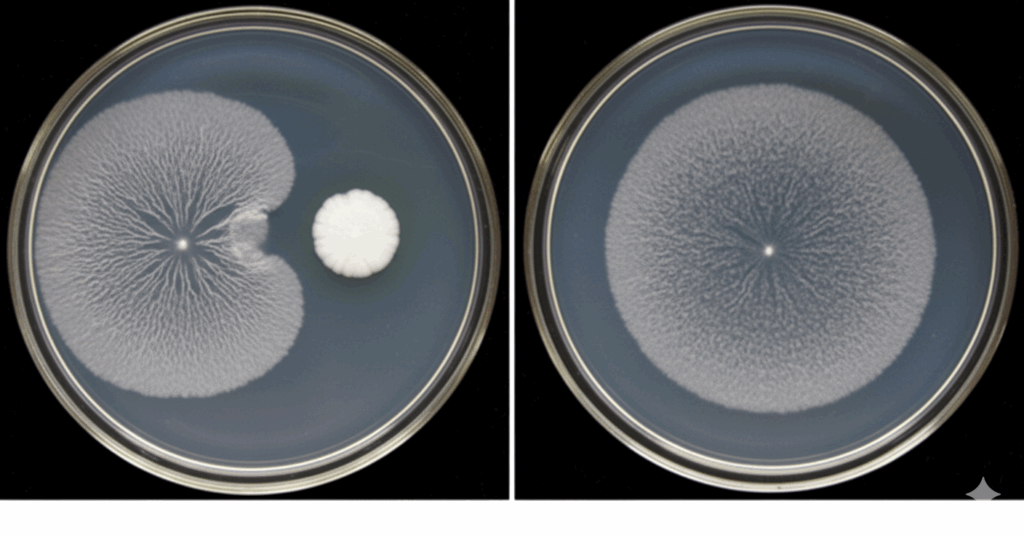

En el sector de la agricultura sostenible y la producción ecológica, Nostoc Biotech se ha consolidado como una empresa referente en la fabricación de biofertilizantes con Bacillus. Sus productos innovadores están transformando la forma en que los agricultores mejoran la salud del suelo y potencian el rendimiento de sus cultivos, aportando resultados visibles. En este artículo, repasamos los principales beneficios del Bacillus durante el otoño y cómo su aplicación en esta época ayuda a preparar el suelo y los cultivos para el invierno.
¿Qué son los biofertilizantes con Bacillus?
Los biofertilizantes basados en bacterias del género Bacillus son microorganismos beneficiosos que mejoran la salud del suelo y la nutrición vegetal de forma natural. Nostoc Biotech, empresa de referencia en la fabricación de microorganismos para la agricultura, ha perfeccionado la producción de estos bioestimulantes, ofreciendo soluciones que combinan eficacia, sostenibilidad y resultados comprobados en campo..
Beneficios de los biofertilizantes en otoño
La temporada otoñal es el momento ideal para aplicar fertilizantes biológicos con Bacillus, y aquí te explicamos por qué:
- Preparación del suelo para el invierno: Los productos de Nostoc ayudan a regenerar la microbiota del suelo tras las cosechas de verano, mejorando su fertilidad natural para los cultivos de invierno y primavera.
- Mayor absorción de nutrientes: Las cepas de Bacillus presentes en los biofertilizantes Nostoc facilitan la solubilización de fósforo y otros nutrientes esenciales, optimizando su aprovechamiento por las plantas durante los meses más fríos.
- Protección contra patógenos: En otoño, la humedad aumenta y con ella el riesgo de enfermedades fúngicas. Los biofertilizantes con Bacillus de Nostoc actúan como agentes de biocontrol, protegiendo las raíces de los cultivos.
- Mejora de la estructura del suelo: La aplicación de estos abonos orgánicos biológicos durante el otoño contribuye a mejorar la agregación del suelo, incrementando su capacidad de retención de agua y aireación.
- Reducción de fertilizantes químicos: Los productos de Nostoc permiten disminuir la dependencia de fertilizantes sintéticos, promoviendo una agricultura más respetuosa con el medio ambiente.
¿Por qué Nostoc es líder en biofertilizantes con Bacillus?
En biofertilización microbiana no vale “lleva Bacillus y ya está”. Lo que marca la diferencia real es: qué cepa estás aplicando, si está registrada oficialmente, si llega viva al suelo y si alguien responde técnicamente cuando la necesitas. Ahí es donde Nostoc Biotech está jugando en otra liga.
1. Simbius: un biofertilizante con cepa registrada propia
Simbius es el biofertilizante de Nostoc formulado con la cepa registrada Bacillus altitudinis NTC/BC/01.
Esto es clave por dos motivos:
- Hablamos de una cepa concreta, estable y documentada, no de un “Bacillus genérico”.
- Esa cepa NTC/BC/01 está registrada oficialmente ante el Ministerio de Agricultura. Eso significa trazabilidad, control y respaldo legal.
Cuando el agricultor compra Simbius, sabe exactamente qué microorganismo está aplicando: Bacillus altitudinis NTC/BC/01. Cuando compra otros “productos con bacilos”, normalmente no sabe ni la especie exacta ni la cepa. Y sin cepa no hay garantía de resultado.
2. Funciones agronómicas de Bacillus altitudinis NTC/BC/01
La cepa NTC/BC/01 se seleccionó por su capacidad de:
- Favorecer la fijación biológica de nitrógeno, ayudando a la planta a disponer de nitrógeno de manera más eficiente.
- Solubilizar fósforo bloqueado en el suelo, haciéndolo más disponible para la raíz.
- Movilizar potasio, mejorando el equilibrio nutricional.
- Estimular el desarrollo radicular y la absorción de nutrientes incluso en condiciones de estrés (calor, falta de agua, etc.).
Esto no es marketing verde. Son mecanismos microbiológicos conocidos en cepas de Bacillus altitudinis y que forman parte del criterio de selección de Nostoc para formular Simbius. Si alguna de estas afirmaciones cambiara en ensayo futuro, se ajusta. Si no se demuestra, no se dice. Ese es el nivel de rigor que estamos vendiendo.
3. Calidad microbiológica que llega al campo
Nostoc trabaja con control de calidad lote a lote para asegurar:
- Viabilidad real de la cepa NTC/BC/01 en el envase.
- Concentración estable de microorganismos vivos, no producto vacío.
- Ausencia de contaminantes indeseados.
Traducción práctica: cuando el técnico recomienda una dosis, esa dosis contiene microorganismo funcional, no “restos de cultivo”.
Esto es otra diferencia respecto a productos sin control microbiológico serio, donde el etiquetado dice una cosa y el análisis de laboratorio luego dice otra.
4. Producción propia y soporte técnico
Nostoc no es un mero distribuidor de producto comprado a un tercero. Nostoc:
- Desarrolla y formula Simbius internamente.
- Mantiene banco de cepas propio.
- Acompaña en campo con asesoramiento técnico (manejo de suelo, momento de aplicación, compatibilidades).
Esto es importante porque el rendimiento real de un biofertilizante microbiano no depende solo de “qué lleva”, sino de cómo y cuándo lo aplicas.
5. Por qué debes comprar Simbius y no “algo parecido”
- Porque sabes qué estás aplicando: Bacillus altitudinis NTC/BC/01 registrada.
- Porque hay una empresa detrás que responde con nombre y apellidos: Nostoc Biotech.
- Porque existe respaldo documental ante el Ministerio, no solo una etiqueta bonita.
- Porque hay ensayos en condiciones comerciales de cultivo, no solo ensayo de laboratorio.
- Porque Simbius no es un genérico: es una formulación diseñada para que la bacteria llegue viva a la raíz y trabaje en el suelo.
En resumen:
Simbius es hoy una de las pocas soluciones en el mercado español donde puedes trazar la cepa (Bacillus altitudinis NTC/BC/01), el origen, la formulación y el uso recomendado. Eso es seguridad agronómica y seguridad legal. Eso es lo que estás pagando cuando compras Nostoc.
Aplicación de biofertilizantes en otoño
Para obtener los mejores resultados con los biofertilizantes de Bacillus durante la estación otoñal, se recomienda:
- Aplicar después de la cosecha, cuando se prepara el terreno para nuevos cultivos
- Incorporar al suelo mediante riego o aplicación directa al sistema radicular
- Combinar con prácticas de labranza mínima para preservar la vida microbiana
- Seguir las dosis recomendadas por el fabricante

Conclusión
Nostoc se ha posicionado como la empresa de referencia en la fabricación de biofertilizantes con Bacillus, ofreciendo productos de alta calidad que responden a las necesidades de la agricultura moderna. Con la llegada del otoño, es el momento perfecto para aprovechar los beneficios de estos fertilizantes orgánicos y preparar el suelo para futuras cosechas exitosas.
La combinación de innovación, sostenibilidad y eficacia convierte a la empresa española Nostoc Biotech en el socio ideal para agricultores que buscan alternativas naturales y efectivas a los fertilizantes convencionales. Apostar por biofertilizantes con Bacillus es invertir en la salud del suelo, la productividad de los cultivos y el futuro de la agricultura sostenible.
